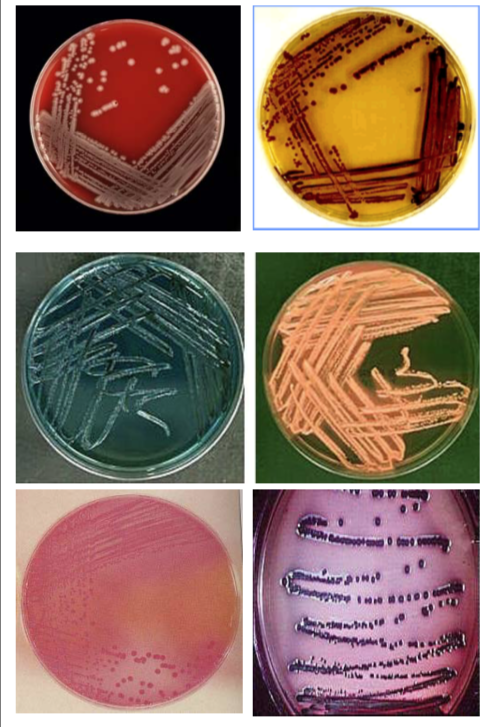
image attached

FOOD AND INDUSTRIAL MICROBIOLOGY: Introduction
Foods and microorganisms have long and interesting associations which developed long before the beginning of recorded history. Foods are not only nutritious to consumers, but are also excellent source of nutrients for microbial growth. Depending upon the microorganisms present, foods may spoil or preserved by fermentation.
Microorganisms can be used to transform raw foods into fermented delights, including yoghurt, cheese, sausages, tempeh, pickles, wine, beers and other alcoholic products. On the other hand, foods also can act as a reservoir for disease transmission, and thus detection and control of pathogens and spoilage organisms are important areas of food microbiology. During the entire sequence of food handling from the producer to the final consumer, microorganisms can affect food quality and human health.
History of microorganisms in food
There is no documentation to exactly pinpoint as to when man first became aware of the presence of microorganisms in food. The year 1674 marks the birth year of microbiology when Leeuwenhoek first examined microorganisms in a sample of lake water. It was after about 100 years when Microbiology was established as science. Several experiments conducted by scientists to explain the origin of microorganisms provided indirect evidence of association of microorganisms in food. The period prior to establishment of Microbiology/ Bacteriology as science is designated as prescientific era which includes a food gathering period and food producing period.
Food gathering period covers time of man's origin about 3 million years up to 8000-10000 years ago. In this period man was carnivorous and plant foods entered his diet later. Man also learnt to cook food during this period also.
Food producing period ranges from 8000- 10000 years ago and includes present time. Many problems related to prepared foods were encountered during this period for example the problem of food spoilage due to improper storage and problem of food poisoning with prepared foods as well as problem of disease transmission by foods. Although scientific basis for the preservation of foods were not known at that time but some of the methods used for preservation were use of oils, snow, smoking of meats, etc.
Perhaps the first man to suggest role of microorganisms in food spoilage was a Monk Kircher who referred to worms in decaying bodies, spoiled milk etc. The observations by Spallanzani that heated meat infusion in a hermetically sealed flask remained unspoiled and free from microorganisms and experiments by Pasteur while disproving the spontaneous generation theory demonstrated the idea of food preservation by heat.
The spoilage of food and presence of food poisoning organisms in food are very important from the point of food safety. Today the emphasis is on total quality of food which means that not only food should be nutritionally balanced but should be microbiologically safe too. In this chapter we will study general principles of microbial spoilage of food, detection and enumeration of food spoilage and food poisoning microorganisms. The spoilage of some important foods and characteristics of important food poisoning organisms which are very important for food safety will also be discussed.
Food Spoilage and General Principles Underlying Spoilage of Food
Spoilage of food involves any change which renders food unacceptable for human consumption and may result from a variety of causes, which includes i) insect damage; ii) physical injury due to freezing, drying, burning, pressure, drying, radiation etc; iii) activity of indigenous enzymes in plant and animal tissues; iv) chemical changes not induced by microbial or naturally occurring enzymes. These changes usually involved O2, light and other than microbial spoilage, are the most common cause of spoilage e.g. oxidative rancidity of fats and oils and the discoloration of cured meats; and v) growth and activity of microorganisms- bacteria, yeasts and molds.
A food unfit for consumption may not necessarily be spoiled and may contain high number of food poisoning causing bacteria. Microbial deterioration of food is evidenced by alteration in the appearance (color changes, pockets of gas/ swelling), texture (soft & mushy), color, odor, and flavor or slime formation.
Since foods are of plant & animal origin, so it is worthwhile to consider those characteristics of plant & animal tissues that affect microbial growth. The plants and animals that serve as food sources have all evolved mechanisms of defense against the invasion and proliferation of microorganisms, and some of these remain in effect in fresh foods. Knowledge of sources of microorganisms and factors influencing microbial growth is necessary for food microbiologists because desirable growth conditions are needed for applicability of microorganisms for fermentation & single cell protein production and understanding of undesirable conditions are used for food preservation. The various sources through which microorganisms gain entry into the foods are shown in Table 1.
Table 1: Primary sources of microorganisms found in foods
| Sources |
| Microflora present in soil and water Microflora present in air Microflora present on plant and plant products Microflora present on Food utensils and equipments Microflora present in animal feeds Microflora present on animal hides Microflora present in Intestinal tracts of humans and animals Food Handlers |
In order to manage microbial contamination and growth from the farm up to the consumer, the Hazard Analysis Critical Control Point (HACCP) approach is widely used. This approach emphasizes monitoring the quality of food ingredients at critical process handling steps. A safe product will result if the individual steps are carefully controlled. Now- a-days HACCP approach has become mandatory for the food processing industries to ensure that safe foods are available to the public.
A variety of intrinsic and extrinsic factors determine whether microbial growth will preserve or spoil foods, as shown in Table. 2. Intrinsic or food related parameters are those parameters of plants and animal tissues which are inherent part of the tissue. e.g., pH, water activity (aw), oxidation-reduction potential (Eh), nutrient content, antimicrobial constituents and biological structures. Extrinsic or environmental parameters are properties of storage environments which affect both foods as well as microorganisms and include temperature of storage, relative humidity of storage environment, and concentration of gases in environment.
Table 2: Factors affecting the development of microorganisms in foods
| Intrinsic Factors | Extrinsic factors | Implicit factors | Processing factors |
|---|---|---|---|
| Nutrient content pH Redox potential Water activity Antimicrobial constituents & barriers | Temperature Relative humidity Gaseous atmosphere | Synergism Antagonism Commensalism Growth rate | Irradiation Washing Slicing Pasteurization Packaging |
Intrinsic Parameters
Nutrient content
Like all other living beings, microorganisms need water, a source of carbon, an energy source, a source of nitrogen, minerals, vitamins and growth factors in order to grow and function normally. Since foods are rich source of these compounds, thus can be used by microorganisms also. It is because of these reasons various food products like malt extracts, peptone, tryptone, tomato juice, sugar and starch are incorporated in microbial media.
The inability to utilize a major component of the food material will limit its growth and put it at a competitive disadvantage compared to those that can. In general, molds have the lowest requirement, followed by yeasts, gram-negative bacteria, and gram-positive bacteria. Many food microorganisms have the ability to utilize sugars, alcohols, and amino acids as sources of energy. Few others are able to utilize complex carbohydrates such as starches and cellulose as sources of energy. Some microorganisms can also use fats as the source of energy, but their number is quite less. The primary nitrogen sources utilized by heterotrophic microorganisms are amino acids. Also, other nitrogenous compounds which can serve this function are proteins, peptides and nucleotides. In general, simple compounds are utilized first by a majority of microorganism’s e.g, amino acids. The same is true for fats and polysaccharides.
Some microorganisms may require B vitamins in small quantities and natural foods have these in abundant quantities for those microorganisms which cannot synthesize them. In general, gram negative bacteria and molds are able to synthesize most or all of their requirements. Consequently, these two groups of organisms may be found growing on foods low in B vitamins. Fruits tend to be low in B vitamins than meats and usually have low pH and positive Eh which explains their spoilage by molds rather than bacteria.
Water Activity (aw)
Water is often the major constituent in foods. Even relatively ‘dry’ foods like bread and cheese usually contain more than 35% water. The state of water in a food can be most usefully described in terms of water activity.
Water activity of a food is the ratio between the vapour pressure of the food, when in a completely undisturbed balance with the surrounding air, and the vapour pressure of pure water under identical conditions. Water activity, in practice, is measured as Equilibrium Relative Humidity (ERH) and is given by the formula:
Water Activity (aw) = ERH / 100
Water activity is an important property that can be used to predict food safety, stability and quality. The various applications of water activity includes; maintaining the chemical stability of foods, minimizing non enzymatic browning reactions and spontaneous autocatalytic lipid oxidation reactions, prolonging the desired activity of enzymes and vitamins in foods, optimizing the physical properties of foods such as texture.
Water activity scale extends from 0 (bone dry) to 1.00 (pure water). But most foods have a water activity in the range of 0.2 for very dry foods to 0.99 for moist fresh foods. Based on regulations, if a food has a water activity value of 0.85 or below, it is generally considered as non-hazardous. This is because below a water activity of 0.91, most bacteria including the pathogens such as Clostridium botulinum cannot grow. But an exception is Staphylococcus aureus which can be inhibited by water activity value of 0.91 under anaerobic conditions but under aerobic conditions, it requires a minimum water activity value of 0.86. Most molds and yeasts can grow at a minimum water activity value of 0.80. Thus a dry food like bread is generally spoiled by molds and not bacteria. In general, the water activity requirement of microorganisms decreases in the following order: Bacteria > Yeast > Mold. Below 0.60, no microbiological growth is possible. Thus the dried foods like milk powder, cookies, biscuits etc are more shelf stable and safe as compared to moist or semi-moist foods.
Factors that affect water activity requirements of microorganisms include the following- kind of solute added, nutritive value of culture medium, temperature, oxygen supply, pH, inhibitors. Each microorganism has a minimal water activity for growth as shown in Table 3. Water activity of some foods and susceptibility to spoilage by microorganisms is shown in Table 4. Water acts as an essential solvent that is needed for most biochemical reactions by the microorganisms. Water activity of the foods can be reduced by several methods: by the addition of solutes or hydrophilic colloids, cooking, drying and dehydration: (e.g., egg powder, pasta), or by concentration (e.g. condensed milk) which restrict microbial growth so as to make the food microbiologically stable and safe.
A wide variety of foods are preserved by restricting their water activity. These include:
Dried or Low Moisture Foods
These contain less than 25% moisture and have a final water activity between 0.0 and 0.60. e.g., Dried egg powder, milk powder, crackers, and cereals. These products are stored at room temperature without any secondary method of preservation. These are shelf stable and do not spoil as long as moisture content is kept low.
Table 3: Minimum water activity values of spoilage microorganisms
| Microbial group | Minimum aw | Examples |
|---|---|---|
| Most bacteria Most yeasts Most molds Halophilic bacteria Xerophilic molds Osmophilic yeasts | 0.91 0.88 0.80 0.75 0.65 0.60 | Salmonella spp., Clostridium botulinum Torulopsis spp. Aspergillus flavus Wallemia sebi Aspergillus echinulatas Saccharomyces bisporus |
Table 4: Water activity of some foods and susceptibility to spoilage by microorganisms
| Water activity | Microorganisms grow at this aw and above | Food examples |
|---|---|---|
| 1.00 - 0.95 | Pseudomonas, E.coli, Proteus, Shigella, Klebsiella, Bacillus, Clostridium perfringens & some yeasts | Highly perishable fresh foods & canned fruits, vegetables, meat, fish, milk, eggs; foods containing up to 40% (w/w) sucrose or 7% NaCl. |
| 0.95 - 0.91 | Salmonella, Vibrio parahemolyticus, Clostridium botulinum, Serratia, Lactobacillus, Pediococcus; some molds and yeasts | Some cheeses (cheddar, Swiss), Cured meats; some fruit juice concentrates; bread; high moisture prunes; foods containing 55%(w/w) sucrose or 12% NaCl |
| 0.91 - 0.87 | Many yeasts like Candida, Torulopsis, Hansenula; Micrococcus | Fermented sausages; sponge cakes; dry cheese; margarine; foods containing 65%(w/w) sucrose (saturated) or 15% NaCl |
| 0.87 - 0.80 | Most molds, Staphylococcus aureus, most Saccharomyces spp., Debaromyces | Most fruit juice concentrates, sweetened condensed milk, flour, rice, pulses containing 15 - 17% moisture, salami |
| 0.80 - 0.75 | Most halophilic bacteria, Mycotoxigenic Aspergilli | Jam, Marmalade, Glace fruits, Soy sauce |
| 0.75 - 0.65 | Xerophilic molds, Saccharomyces bisporus | Rolled oats containing 10% moisture; Fudge; Marshmallows; Jelly; Some dried fruits; Nuts, Peanut Butter |
| 0.65 - 0.60 | Osmophilic yeasts, Few molds | Dried fruits containing 15 - 20% moisture; Honey |
| 0.50 | No microbial proliferation | Pasta containing 12% moisture; Spices containing 10% moisture |
| 0.40 | No microbial proliferation | Whole egg powder containing 5% moisture |
| 0.30 | No microbial proliferation | Cookies, biscuits crackers, bread crusts etc. containing 3 - 5% moisture |
| 0.20 | No microbial proliferation | Whole milk powder containing 2 - 3% moisture, Dried vegetables containing 5% moisture, Corn flakes containing 5% moisture, Instant coffee |
Intermediate Moisture Foods
These foods contain between 15% and 50% moisture content and have a water activity between 0.60 and 0.85. These foods normally require added protection by secondary methods such as pasteurization, pH control, refrigeration, preservatives, but they can also be stored at room temperature. These include dried fruits, cakes, pastries, fruit cake, jams, syrups and some fermented sausages. These products are usually spoiled by surface mold growth.
pH and Buffering capacity
The pH, or hydrogen ion concentration, [H+], of natural environments varies from about 0.5 in the most acidic soils to about 10.5 in the most alkaline lakes. Since the pH is measured on a logarithmic scale, the [H+] of natural environments varies over a billion-fold and some microorganisms are living at the extremes, as well as every point between the extremes. The range of pH over which an organism grows is defined by three cardinal points: the minimum pH, below which the organism cannot grow, the maximum pH, above which the organism cannot grow, and the optimum pH, at which the organism grows the best. Microorganisms which grow at an optimum pH well below neutrality (7.0) are called acidophiles. Those which grow best at neutral pH are called neutrophiles and those that grow best under alkaline conditions are called alkalophiles. In general, bacteria grow faster in the pH range of 6.0- 8.0, yeasts 4.5-6.5 and filamentous fungi 3.5-6.8, with the exception of lactobacilli and acetic acid bacteria with optima between pH 5.0 and 6.0 (Table 5). The approximate pH ranges of some common food commodities are shown in Table 6.
Table 5: Approximate pH ranges of different microbial groups
| Minimum | Optimum | Maximum | |
|---|---|---|---|
Most Bacteria | 4.5 | 6.5 - 7. | 9.0 |
| Product | pH |
|---|---|
| Citrus fruits Soft drinks Apples Bananas Beer Meat V egetables Fish ( most spp) Milk Wheat flour Egg white Fermented shark | 2.0-5.0 2.5-4.0 2.9-3.3 4.5-4.7 3.5-4.5 5.6-6.2 4.0-6.5 6.6-6.8 6.5-6.8 6.2-6.8 8.5-9.5 10.5-11.5 |
The acidity of a product can have important implications for its microbial ecology, and the rate and character of its spoilage. For example, vegetables generally have a moderately acidic pH and thus are spoiled by soft-rot producing bacteria such as Erwinia carotovora and pseudomonads, while in fruits, a lower pH prevents bacterial growth and spoilage is caused by yeasts and molds. Also, fish spoil more rapidly as compared to meat under chill conditions. The pH of meat (5.6) is lower than that of fish (6.2-6.6) and this contributes to the longer storage life of meat. The pH- sensitive genus Shewanella plays an important role in fish spoilage but has not been reported in normal meat (pH<6.0).
The natural or inherent acidity of foods may be thought of as nature’s way of protecting the respective plant or animal tissues from destruction by microorganisms. Thus, the ability of low pH to restrict microbial growth has been deliberately employed since long in the preservation of foods with acetic and lactic acids.
Redox Potential (Eh)
Microorganisms display varying degrees of similarity to Oxidation-Reduction potential of their growth medium. The O/R potential is the measure of tendency of a revisable system to give or receive electrons. When an element or compound looses electrons, it is said to be oxidized, while a substrate that gains electrons becomes reduced. Thus a substance that readily gives up electrons is a good reducing agent, while one that readily gains electrons is a good oxidizing agent. When electrons are transferred from one compound to another, a potential difference is created between the two compounds and is expressed in as millivolts (mV). If a substance in more highly oxidized, the more positive will be its electrical potential and vive versa. The O/ R potential of a system is expressed as Eh. Aerobic microorganisms require positive Eh values for growth while anaerobic microorganisms require negative Eh values (reduced). The redox potential we measure in a food is the result of several factors: redox couples present, ratio of oxidant to reductant, pH, poising capacity, availability of oxygen and microbial activity. Some redox couples typically encountered in food material and their standard redox potential (Eh) values are shown in Table 7.
Table 7: Some important redox couples and their standard redox potential (Eh) values
| Couple | E0 (mV) |
|---|---|
| 1⁄2 O2/H2O Fe[3]+/Fe[2]+ Dehydroascorbic acid / ascorbic acid Methylene blue ox/ red Pyruvate/ lactate NAD+/NADH | +820 +760 +80 +11 -190 -320 |
With the exception of oxygen, most of the couples present in foods, e.g, glutathione, cysteine, ascorbic acid and reducing sugars tend to establish reducing conditions. pH of the food has a bearing on the redox potential and for every unit decrease in the pH the Eh increases by 58 mV (Table 8). As redox conditions change there will be some resistance to change in food’s Eh, and is known as poising and is similar to buffering of the medium. Poising is maximum when the two redox couples are present in equal amounts. Oxygen is the most powerful of redox couple present in food system and if the food is stored in the presence of air, high positive potential will result. Thus, increasing the access to air by mincing, cutting, chopping, grinding of food will increase the Eh as evident by high positive Eh of minced meat as compared to raw meat ( Table 8). Finally microbial growth in the food reduces the Eh due to oxygen depletion. The decrease in Eh due to microbial activity forms the basis of some tests used frequently in raw milk such as MBRT as described later in the chapter.
Table 8: Redox potential of some foods| Food | Eh(mV) | pH |
|---|---|---|
Raw meat | -200 | 5.7 |
Antimicrobial constituents and barriers
Some foods can resist the attack by microorganisms due to presence of certain naturally occurring substances which possess antimicrobial activity such as essential oils in spices ( eugenol in cloves and cinnamon, allicin in garlic, cinnamic aldehyde in cinnamon, thymol in sage); lactaferrin, lactoperoxidase and lysozyme in milk; and ovatransferrin, avidin, lysozyme and ovoflavoprotein in hen’s egg albumin. Similarly, casein as well as free fatty acids found in milk also exhibit antimicrobial activity. The hydroxycinnamic acid derivatives (p-coumaric, feluric, caffeic and chlorogenic acids) found in fruits, vegetables, tea and other plants possess antibacterial and antifungal activity. Also natural covering of foods like shell of eggs and nuts, outer covering of fruits and testa of seeds, hide of animals provide protection against entry and subsequent spoilage by microorganisms.
Extrinsic Parameters
Temperature of storage
Microorganisms have been found growing in virtually all temperatures. A particular microorganism will exhibit a range of temperature over which it can grow, defined by three cardinal points in the same manner as pH considering the total span of temperature where liquid water exists, the prokaryotes may be subdivided into several subclasses on the basis of one or another of their cardinal points for growth. For example, organisms with an optimum temperature near 37 degrees are called mesophiles. Organisms with an optimum temperature between about 45 degrees and 70 degrees are thermophiles e.g, Bacillus, Clostridium etc. Some archaebacteria with an optimum temperature of 80 degrees or higher and a maximum temperature as high as 115 degrees, are now referred to as extreme thermophiles or hyperthermophiles. The cold-loving organisms are psychrophiles defined by their ability to grow at 0 degrees. A variant of a psychrophile (which usually has an optimum temperature of 10-15 degrees) is a psychrotroph, which grows at 0 degrees but displays an optimum temperature in the mesophile range, nearer room temperature. Psychrotrophs are the scourge of food storage in refrigerators since they are invariably brought in from their mesophilic habitats and continue to grow in the refrigerated environment where they spoil the food. Of course, they grow slower at 2 degrees than at 25 degrees. Think how fast milk spoils on the counter top versus in the refrigerator. In food microbiology mesophilic and psychrotrophic organisms are of greatest importance.
Relative Humidity of the storage environment
Relative humidity and water activity are interrelated. When foods with low aw are stored in environment of high humidity, water will transfer from the gas phase to the food and thus increasing the aw of the food leading to spoilage by the viable flora. There is a relationship between temperature and humidity which should be kept in mind. In general, the higher the temperature, lower is the relative humidity and vice-versa. Foods that undergo surface spoilage from molds, yeasts, and some bacteria should be stored in conditions of low relative humidity to increase their shelf life. This can also be done by proper wrapping of the food material also. However, variations in storage temperature should be minimal to avoid surface condensation in packed foods.
Gaseous atmosphere
Oxygen is one of the most important gases which come in contact with food influence the redox potential and finally the microbial growth as discussed earlier. The inhibitory effect of CO2 on the growth of microorganisms is applied in modified atmosphere packaging of foods. The storage of foods in atmosphere containing 10% of CO2 is referred to as “Controlled Atmosphere”. This type of treatment is applied more commonly in case of fruits such as apples and pears. With regards to the effect of CO2 on microorganisms, molds and Gram-negative bacteria are the most sensitive, while the gram-positive bacteria, particularly the lactobacilli are tend to be more resistant. Some yeasts such as Bretanomyces spp also show considerable tolerance of high CO2 levels and dominates the spoilage microflora of carbonated beverages. Some microorganisms are killed by prolonged exposure to CO2 but usually its effect is bacteriostatic. Also, the presence of CO2 tends to decrease the pH of foods and thereby inhibiting the microorganisms present in it by adversely affecting the solute transport, inhibition of key enzymes involved in carboxylation/ decarboxylation reactions.
Microbial Spoilage of Foods
Most foods serve as good growth medium for many different microorganisms. Considering the variety of foods and the methods used for processing, it is apparent that practically all kinds of microorganisms are potential contaminants. Given a chance to grow, the microorganisms will cause changes in appearance, flavor, odour and other qualities of foods. These degradation processes includes:
Putrefaction:
Protein foods + proteolytic microorganisms ==> amino acids +amines+ ammonia+ H2S.Fermentation:
Carbohydrate foods +saccharolytic microorganisms ==> organic acids + alcohol + gases.
Rancidity:
Fatty foods + lipolytic microorganisms ==> fatty acids + glycerol.
Microorganisms cause spoilage not only by degradation of foods, but also by synthesis of various products like pigments and polysaccharides leading to discolorations and formation of slimes. The common spoilage defects that occur in different foods with some examples are shown in Table 9.
Table 9: Types of food spoilage with some examples of casual organisms
| Food | Types of Spoilage | Microorganisms involved |
| Bread | Moldy Ropy | Rhizopus nigricans, Penicillium Bacillus subtilis |
| Pickles, Sauerkraut | Film/ Pink Yeasts | Rhodotorula |
| Fresh Meats | Putrefaction | Alcaligenes, Clostridium, Proteus vulgaris, Pseudomonas fluorescens |
| Cured Meats | Moldy | Rhizopus, Aspergillus, Penicillium |
| Fish Poultry Eggs | Discolorations, Slime, Odor Colorless & Green Rots | Alcaligenes, Pseudomonas, Flavobacterium Alcaligenes, Pseudomonas Alcaligenes, Proteus, Pseudomonas, P. fluorescens |
| Concentrated Juices | ‘Off’ flavor | Acetobacter, Lactobacillus, Leuconostoc Rhizopus, Erwinia |
| Fresh fruits and vegetables | Soft rots | Botrytis, Aspergillus niger |
| Milk/ Cream | Gray & black mold Ropiness | Alcaligenes viscolactis, Micrococcus, Enterobacter, Lactobacillus, Streptococcus, Bacillus |
| Decomposition of fats | Yeasts, molds, Alcaligenes, Proteus, Pseudomonas, Micrococcus, Bacillus, Clostridium | |
Alkali formers Flavor changes | Alcaligenes viscolactis, P. fluorescens Lactobacillus,Streptococcus, Leuconostoc |
Spoilage of fresh and ready-to-eat meat products
Raw Meat
Meats are the perishable of all important foods because of abundance of nutrients and moisture content. Fresh meats from food animals and birds contain a large group of potential spoilage bacteria that include species of Pseudomonas, Acinetobacter, Moraxella, Shewanella, Alcaligenes, Escherichia, Enterobacter, Serratia, Hafnia, Proteus, Brochothrix, Micrococcus, Enterococcus, Lactobacillus, Leuconostoc, Carnobacterium, and Clostridium, as well as yeasts and molds. The kind and amount of spoilage of meat depends upon the availability of nutrients, presence of oxygen, temperature of storage, pH, the storage time of the product, and the generation time of the spoilage microorganisms under a given environment. Post-rigor meats are rich in non-protein nitrogenous compounds, peptides and proteins, but low in carbohydrates, with a pH of about 5.5 and Aw > 0.97.
In order to prevent microbial spoilage, fresh meats are stored at refrigerated temperature (≤ 5°C). Thus normally psychrotrophic bacteria will be the most predominant types in raw meat spoilage. Under aerobic storage at low temperature, growth of psychrotrophic aerobes and facultative anaerobes is favored e.g, Pseudomonas spp. In meats with high pH and/or low glucose content, Acinetobacter and Moraxella, which preferentially metabolize amino acids instead of glucose, can grow rapidly and produce undesirable odors. The various spoilage defects of meats are shown in Table 10.
Table 10: Different types of spoilage of meats| Aerobic or Anaerobic spoilage | Defect | Microorganisms involved |
| Aerobic (Bacterial) | Surface Slimes | Alcaligenes,Pseudomonas,Lactobacillus, Leuconostoc, Micrococcus, Bacillus Lactobacillus, Leuconostoc Pseudomonas, Achromobacter Photobacterium spp |
Bloom of Discolorations Rancidity Phosphorescence | Serratia marcescens | |
| Yellow discolorations Off-odors off-tastes (Taints) | Micrococcus, Flavobacterium Lactic acid bacteria, Actinomycetes | |
| Aerobic (Yeasts) | Discolorations/Taints/ sliminess/ lipolysis | Rhodotorula |
| Aerobic (Molds) | Stickiness | Rhizopus, Aspergillus, Penicillium |
| Anaerobic (Bacterial) | Souring | Clostridium spp |
In vacuum-packaged meats, psychrotrophic facultative anaerobes and obligate anaerobes can grow and result in different types of spoilage. Lactobacillus curvatus and Lb. sake metabolize glucose to produce lactic acid and the amino acids leucine and valine to volatile fatty acids like isovaleric and isobutyric acids which impart a cheesy flavor in meat. Heterofermentative Leuconostoc carnosum and Leuconostoc gelidum produce CO2, and small quantity of lactic acid, causing accumulation of gas and liquid in the package. Facultative anaerobic Enterobacter, Serratia, Proteus, and Hafnia species metabolize amino acids while growing in meat to produce amines, ammonia, methylsulfides, and mercaptans, and cause putrefaction. Some strains also produce H2S in small amounts to cause greening of the meat. Shewanella putrefaciens, which can grow under both aerobic and anaerobic conditions, metabolizes amino acids (particularly cysteine) to produce methylsulfides and H2S in large quantities. Along with offensive odors they adversely affect the normal color of meats. H2S oxidizes myoglobin to a form of metmyoglobin, causing a green discoloration.
To reduce spoilage of' Fresh meats, storage at low temperatures (~ 0 to 1°C), modified atmosphere packaging, and vacuum packaging are extensively used. Several other methods to reduce initial microbial load and slow down growth of Gram-negative rods have been used which include the addition of small amounts of organic acids to lower the pH of meat (slightly above pH 5.0), drying of meat surfaces (to reduce aW), and a combination of the above factors including lower storage temperature.
Ready-to-Eat Meat Products
Ready-to-Eat Meat Products includes high heat-processed and low heat-processed uncured and cured meat products. High heat-processed cured and uncured meats are given heat treatment to make them commercially sterile. Thus they may only have some thermophilic spores surviving, which will not germinate unless the products are temperature abused. Low heat-processed uncured meats, such as roasts, are given heat treatment ranging from 140 to 150°F internal temperature (60 to 65°C) for 1h or more depending upon the size of the meat. Under this condition, only the spores of Bacillus and Clostridium spp. and some extremely thermoduric species like Lactobacillus viridescens, some Enterococcus, Micrococcus can survive. Many other types of microorganisms can enter into the products from equipment, personnel, and air as post-heat contaminants. Also, spices and other ingredients added to the products can add to the microbial contamination of the products. Psychrotrophic facultative anaerobic and obligate anaerobic bacteria have been implicated in the spoilage of these products. Gas production and purge accumulation by psychrotrophic Clostridium spp., along with off flavor and color changing from brown to pink to red have been detected. The vacuum-packaged and gas- packaged products, during storage, can be spoiled by psychrotrophic Lactobacillus and Leuconostoc spp. In some products, growth of Serratia liquifaciens causes amino acid breakdown, leading to production of ammonia-like flavor. In case of unpackaged cooked products putrefaction results from the growth and protein degradation by the proteolytic Gram- positive bacteria. If the products are stored for a long time, yeasts and molds can also grow, causing off-flavour, discoloration, and sliminess. Due to the growth of H2O2-producing lactic acid bacteria, the products may have green to gray discoloration.
Spoilage of milk and milk products
Raw Milk
Raw milk contains many types of microorganisms coming from different sources. The average composition of cow's milk is 3.2% protein, 4.8% carbohydrates, 3.9% lipids, and 0.9% minerals. Besides casein and lactalbumin, it has free amino acids that provide a good N-source. As the main carbohydrate is lactose, those microorganisms with lactose-hydrolyzing enzymes (lactase or β-galactosidase) have an advantage over those unable to metabolize lactose. Milk fat can be hydrolyzed by microbial lipases, with the release of small molecular volatile fatty acids (butyric, capric, and caproic acids). The various spoilage defects of milk and milk products are shown in Table 9.
Microbial spoilage of raw milk can potentially occur from the metabolism of lactose, proteinaceous compound, fatty acids (unsaturated), and the hydrolysis of triglycerides. If the milk is refrigerated immediately following milking and stored for days, the spoilage will be predominantly caused by the Gram-negative psychrotrophic rods, such as Pseudomonas, Alcaligenes, Flavobacterium spp., and some coliforms. Pseudomonas and related species, being lactose-negative, will metabolize proteinaceous compounds to change the normal flavor of milk to bitter, fruity, or unclean. The growth of lactose-positive coliforms will produce lactic, acetic, and formic acids, CO2, and H2 leading to curdling and souring of milk. Some Alcaligenes spp and coliforms can also cause ropiness (sliminess) due to production of viscous polysaccharides. However, if the raw milk is not refrigerated soon, growth of mesophiles predominates e.g, Lactococcus, Lactobacillus, Enterococcus, Bacillus, and coliforms, along with Pseudomonas, Proteus, and others causing changes like souring and curdling of milk. Yeast and mold growth, under normal conditions, is generally not expected.
Pasteurized Milk
Pasteurized milk contains various thermoduric bacteria like Micrococcus, Enterococcus, Lactobacillus, Streptococcus, Corynebacterium, and spores of Bacillus and Clostridium which survive pasteurization process. In addition, coliforms, Pseudomonas, Alcaligenes, and Flavobacterium etc can enter as post-pasteurization contaminants. Thus, pasteurized milk has a limited shelf life under refrigerated storage mainly due to growth of these psychrotrophic contaminants. The spoilage pattern of pasteurized milk is the same as described for raw milk. Flavor defects from their growth are detectable when the population reaches ≥106 cells/ml. Growth of psychrotrophic Bacillus spp., such as Bacillus cereus, has been implicated in the spoilage of pasteurized refrigerated milk, especially when the levels of post-pasteurization contaminants are low. Production of rennin-like enzymes by the psychrotrophs can cause sweet curdling of milk at higher pH than required for acid curdling.
Ultrahigh temperature-treated milk (150°C for a few seconds) is an essentially commercially sterile product that can only contain viable spores of some thermophilic bacteria. The milk is not susceptible to spoilage at ambient storage temperature, but can be spoiled if exposed to high temperatures as such with canned foods.
Concentrated Liquid Products
Evaporated milk, condensed milk, and sweetened condensed milk are principal types of concentrated dairy products that are susceptible to limited microbial spoilage during storage. All these products are given sufficient heat treatments to kill vegetative microorganisms as well as spores of molds and some bacteria.
Evaporated milk is condensed whole milk with 7.5% milk fat and 25% total solids. It is packaged in hermetically sealed cans and heated to obtain commercial sterility. Under proper processing conditions, only thermophilic spores of spoilage bacteria Bacillus species, such as B. coagulans, can cause coagulation of milk.
Condensed milk is generally condensed and has about 10 to 12% fat and 36% total solids. The milk is initially given a low heat treatment, close to pasteurization temperature, and then subjected to evaporation under partial vacuum (at about 50°C). Thus only thermoduric microorganisms can grow and cause spoilage. Other microorganisms can also get into the product during the condensing process.
Sweetened condensed milk contains about 8.5% fat, 28% total solids, and 42% sucrose. The milk is initially heated to a high temperature (80 to 100°C) and then condensed at about 60°C under vacuum and put into containers. It is susceptible to spoilage from the growth of osmophilic yeasts like Torula spp, causing gas formation. If the containers have enough head space and oxygen, molds (e.g., Penicillium and Aspergillus) can grow on the surface which gains entry into the product by recontamination after heat treatment.
Butter
Butter contains 80% milk fat and can be salted or unsalted. The microbiological quality of butter depends upon the quality of cream and the sanitary conditions used in the processing. Growth of bacteria (Pseudomonas spp.), yeasts (Candida spp.), and molds (Geotrichum) on the surface have been implicated in flavor defects (putrid, rancid, or fishy) and surface discoloration. In unsalted butter, coliforms, Enterococcus, and Pseudomonas can grow favorably in water-phase and produce flavor defects.
Spoilage of fruits and vegetables
V egetables
The main sources of microorganisms in vegetables are soil, water, air, and other environmental sources, and can include some plant pathogens. Fresh vegetables are fairly rich in carbohydrates (5% or more), low in proteins (about 1 to 2%), and, except for tomatoes, have high pH. Microorganisms grow more rapidly in damaged or cut vegetables. The presence of air, high humidity, and higher temperature during storage increases the chances of spoilage. The common spoilage defects are caused by molds belonging to genera Penicillium, Phytophthora, Alternaria, Botrytis, and Aspergillus. Among the bacterial genera, species from Pseudomonas, Erwinia, Bacillus, and Clostridium are important.
Microbial vegetable spoilage is generally described by the common term rot, along with the changes in the appearance, such as black rot, gray rot, pink rot, soft rot, stem-end rot (Table 11)
Refrigeration, vacuum or modified atmosphere packaging, freezing, drying, beat treatment, and chemical preservatives are used to reduce microbial spoilage of vegetables.
Table 11: Common spoilage defects of fruits and vegetables
| Defect | Casual organism |
|---|---|
| Bacterial soft rot Gray mold rot Rhizopus soft rot Blue mold rot Alternaria rot Pink mold rot Green mold rots Watery soft rot, Brown rot Downy mildew Sliminess or souring Black rot/ smut/ Black mold Anthracnose | Erwinia carotovora |
Fruits
Fresh fruits have high carbohydrate content (10% or more), very low protein (≤10%), but have pH 4.5 or below. Thus microbial spoilage of fruits and fruit products is confined to molds, yeasts, and aciduric bacteria like lactic acid bacteria, Acetobacter, Gluconobacter. Like fresh vegetables, fresh fruits are susceptible to rot by different types of molds from genera Penicillium, Aspergillus, Alternaria, Botrytis, Rhizopus, and others. According to the changes in appearance, the mold spoilages are designated as black rot, gray rot, soft rot, brown rot, and others (Table 11). Yeasts Saccharomyces, Candida, Torulopsis, and Hansenula cause fermentation of some fruits such as apples, strawberries, citrus fruits, and dates. Bacterial spoilage associated with the souring of berries and figs has been attributed to the growth of lactic acid and acetic acid bacteria. To reduce spoilage, fruits and fruit products are preserved by refrigeration, freezing, drying, and reducing aW, vacuum packaging and heat treatment (Fig. 1).
Fermented Vegetable and Fruit Products
Fermented vegetables like pickles/cucumber and sauerkraut are produced in large volumes. In salt stock pickles containing about 15% salt, yeasts and halophilic bacteria can grow, especially if the acidity is not sufficient. Dill pickles with low salt (<5%) can have a bloating defect from CO2 production by yeasts (Candida, Torulopsis, and Saccharomyces spp), Heterofermentative lactic acid bacteria, and coliforms. Sweet and sour pickles preserved with sugar and vinegar can be spoiled by yeasts and lactic acid bacteria, if the acid level is not sufficient. Sauerkraut can be spoiled from the growth of yeasts and molds if the air is not excluded during fermentation of cabbage. Also, coliforms and other Gram-negative bacteria can multiply to produce undesirable flavor and texture and color defects. Olives are fermented for a long time and are susceptible to many types of spoilage defects such as gassiness (bloating) due to CO2 production by heterofermentative lactic acid bacteria, coliforms, and yeasts.
 Fig. 1: Spoilage defects of fruits & vegetables A) Watery soft rot in apple caused by Sclerotinia sclerotiorum; B) Blue mould rot in tomato caused by Penicilliumi spp.; C) Storage rot in strawberry caused by Botrytis cinerea; D) Strawberries preserved by vacuum packaging and freezing.
Fig. 1: Spoilage defects of fruits & vegetables A) Watery soft rot in apple caused by Sclerotinia sclerotiorum; B) Blue mould rot in tomato caused by Penicilliumi spp.; C) Storage rot in strawberry caused by Botrytis cinerea; D) Strawberries preserved by vacuum packaging and freezing.
Spoilage of canned foods
Canned foods are heat treated to kill microorganisms present and the extent of heat treatment is predominantly dependent on the pH of a food. High pH (> 4.6/ low acid) foods are heated to destroy most heat-resistant spores of pathogenic bacteria, Clostridium botulinum, to ensure that a product is free of any pathogen. However, spores of some spoilage bacteria, which have greater heat resistance, can survive. Such products are called commercially sterile foods. The other food group designated as low pH or high acid food with pH 4.6 and below, is given heat treatment to kill all vegetative cells and some spores. Although low pH will inhibit germination and growth of C. botulinum, spores of some aciduric thermophilic spoilage bacteria can germinate and grow when the products are stored at higher temperatures, even for a short time, which facilitates germination. Some spores of thermoduric mesophilic spoilage bacteria (including pathogenic) can also survive, heating in these products, but they are inhibited by the low pH.
Canned food spoilage is due both to nonmicrobial (chemical and enzymatic reactions) and microbial reasons. Production of hydrogen (hydrogen swell), CO2, browning, corrosion of cans due to chemical reactions and liquification, gelation, discoloration of products due to enzymatic reactions are some examples of nonmicrobial spoilage. Microbial spoilage is due to three main reasons:
inadequate cooling after heating or high-temperature storage, allowing germination and growth of thermophilic spore formers;
inadequate heating, resulting in survival and growth of mesophilic microorganisms; and
leakage (microscopic) in the cans, allowing microbial contamination from outside
following heat treatment and their growth.
Thermophilic Sporeformers
Thermophilic sporeformers can cause three types of spoilage of low-acid foods such as corn, beans, peas etc when the cans are temperature abused at 43°C and above, even for short duration.
1. Flat Sour Spoilage
In this type of spoilage, the cans do not swell but the products become acidic due to growth of facultative anaerobic Bacillus stearothermophilus. The organism ferments carbohydrates to produce acids without gas.
2. Thermophilic Anaerobe (TA) Spoilage
This type of spoilage occurs due to the growth of anaerobic Clostridium thermosaccharolyticum which leads to the production of large quantities of H2 and CO2 gas and swelling of cans.
3. Sulfide Stinker Spoilage
Gram-negative anaerobic sporeformer Desulfotomaculum nigrificans is responsible for this type of spoilage. The spoilage is characterized by flat container but darkened products with the odor of rotten eggs due to H2S produced by the bacterium.
Spoilage Due to Insufficient Heating
Insufficient heat treatment results in the survival of mainly spores of Clostridium and some Bacillus spp. Following processing, they can germinate and grow to cause spoilage. The most important concern is the growth of C. botulinum and production of toxins. Spoilage can be either from the breakdown of carbohydrates or proteins. Several Clostridium spp., ferment carbohydrates to produce volatile acids and H2 and CO2 gas, causing swelling of cans. Proteolytic species, metabolize proteins and produce foul-smelling H2S, mercaptans, indole, ammonia, as well as CO2 and H2 (causing swelling of cans).
Spoilage Due to Container Leakage
Leakage of containers during transport will allow different types of microorganisms to get inside the can. They can grow in the food and cause different types of spoilage depending upon the microbial types. Contamination with pathogens will make the product unsafe.
Major Food Borne Infections/ Intoxications Caused by Bacteria
What is food borne disease?
Safe, nutritious foods are essential to human health and well-being. However, food-borne diseases pose a significant problem worldwide. Foodborne disease is any illness resulting from the consumption of food contaminated with one or more disease-producing agents. These include bacteria, parasites, viruses, fungi and their products as well as toxic substances not of microbial origin (Table 12). The World Health Organization (WHO) estimates that 1.5 billion cases of food-borne illnesses cause about 3 million deaths each year costing up to $40 billion in health care and job-related absenteeism. More than 250 different food borne diseases have been described. These different diseases have many different symptoms, so there is no one "syndrome" that can be indicated as specific to food borne illness. However, the microbe or toxin enters the body through the gastrointestinal tract, and often causes the first symptoms there, so nausea, vomiting, abdominal cramps and diarrhea is common symptoms in many food borne diseases.
Table 12: Possible causes of food borne gastro intestinal disorders
- Viable pathogenic micro organisms (Bacteria, viruses, fungi) or their preformed toxins
- Pathogenic algae, parasites, protozoa and their preformed toxins
- Toxins naturally present or formed in some foods e.g, toxic mushrooms, some sea foods, red kidney bean poisoning, biological amines in cheese and fermented meats etc.
- Toxic chemicals in contaminated food and water, such as heavy metal and some pesticides
- Nutritional disorders such as rickets due to calcium deficiency
- Allergy to or inability to utilize some normal components of food
- Indigestion from over eating or other reasons
Types of Microbial Food Borne Diseases
On the basis of mode of illnesses, food borne disease (FBD) can be arbitrarily divided into three groups. A more correct classification is shown in Fig. 2.
Intoxication
Illness in this case occurs as a consequence of ingestion of a pre formed bacterial or a mold toxin due to its growth in a food. A toxin has to be present in the contaminated food. Once the micro organism have grown and produced toxin in a food, there is no need of viable cells during the consumption of the food for illness to occur .e.g, Staphylococcal food poisoning.
Infection
Illness occurs as a result of the consumption of food and water contaminated with enteropathogenic bacteria. It is necessary for the cells of enteropathogenic bacteria to remain alive in the food or water during consumption. The viable cells even if present in small numbers have the potential too establish and multiply in the digestive tract to cause the illness. e.g, Salmonellosis.
Toxicoinfection
Illness occurs from the ingestion of a large number of viable cells of some pathogenic bacteria through contaminated food and water. Generally the bacterial cells either sporulate or die and release toxin(s) to produce the symptoms. e.g. Bacillus cereus Gastroenteritis.

Fig. 2: Classification of food borne diseases
The other bacterial hazards responsible for food borne diseases are shown in Table 13 .The main factors responsible for the food borne illness includes:
- a) Improper holding temperature during processing. b) Inadequate cooling during storage.
- c) Contaminated equipments and utensils.
- d) Food from unsafe source.
- e) Poor personal hygiene.
- f) Adding contaminated ingredients to cooked foods.
A detailed account of major bacterial pathogens is as follows:
1) Staphylococcal Food Poisoning
Caused by bacterium Staphylococcus aureus, Staphylococcal Food Poisoning is one of the most common types of food poisoning.
Biology of Staphylococcus aureus
Staphylococcus aureus is a spherical bacterium (coccus) which on microscopic examination appears singly, in pairs, or bunched, grape-like clusters (Fig. 3). They are Gram-positive, facultative anaerobes, but grow rapidly under aerobic conditions. They are mesophiles with a growth temperature range of 7 to 480C and have the ability to grow at low aW (0.86), low pH (4.8), and high salt and sugar concentrations of 15% and in the presence of NO2. S. aureus are naturally present in the nose, throat, skin, and hair of healthy humans, animals and birds. They can be present in infections such as cuts, wounds, abscesses and facial acne etc. The contamination generally occurs through these sources because of improper handling by infected persons.
Table 13: Bacteria responsible for food borne illness
Vibrio parahemolyticus| Type of disease | Causative bacteria | Kind and nature of the bacteria | Major symptom(s) type |
|---|---|---|---|
Intoxication | | | |
| Botulism | Clostridium botulinum strains | Anaerobic, Gram-positive spore forming rod. | Non-gastric |
| Infection Salmonellosis | Over 2000 Salmonella spp. (except S. typhi and S. paratyphi) | Rod shaped, motile, non spore forming Gram-negative bacteria | GIT |
| Campylobacter enteritis | Campylobacter jejuni & Cam. coli strains | Gram-negative, slender, curved, motile, microaerophillic rod | GIT |
| Yersiniosis | Yersinia enterocolitica | Small rod-shaped, Gram-negative bacterium | GIT |
| Enterohemorrhagic E. coli colitis | E. coli 0157:H7 | Gram-negative, motile, non- sporulating, rod shaped facultative anaerobic bacterium. | GIT and non-gastric |
| Non-hemorrhagic E. coli strains | Shiga-like toxin producing E. coli strains like E. coli 026: H11 | Gram-negative, motile, non- sporulating, rod shaped facultative anaerobic bacterium. | GIT |
| Listeriosis Shigellosis | Listeria monocytogenes Four shigella spps. e.g. Sh. dysenteriae | Motile, Gram-positive bacteria Gram-negative, non-motile, non- spore forming rods. | GIT and non-gastric GIT |
| Vibrio parahemolyticus gastroenteritis | Vibrio parahemolyticus | Gram-negative, curved bacteria | GIT |
Vibrio vulnificus infection | Vibrio vulnificus | Lactose-fermenting, halophilic, gram-negative, opportunistic pathogen. | GIT |
| Brucellosis | Brucella abortus | Gram-negative bacteria | GIT and non-gastric |
Toxicoinfection | | anaerobic, Gram-positive, spore forming rod | GIT |
| Bacillus cereus gastroenteritis | Bacillus cereus | Gram-positive, facultative aerobic spore former rods | GIT |
| E. coli gastroenteritis | Enteropathogenioc and enterotoxigenic E. coli | Gram-negative, motile, non-sporulating, rod shaped, facultative anaerobic bacterium | GIT |
| Cholera | Vibrio cholerae | Gram-negative, curved bacteria | GIT |
| Gastroenteritis by opportunististic pathogens Aeromonas hydrophila gastroenteritis | Aeromonas hydrophila | Gram-negative bacteria | |
Plesiomonas shigelloides gastroenteritis | Plesiomonas shigelloides | Gram-negative, rod-shaped bacterium | GIT |
GIT - Gastro-intestinal tract

Fig. 3: Staphylococcus aureus (a) cells (b) colonies on Baird Parker Agar
Toxins, Disease and Symptoms
Only certain strains of S. aureus can cause food poisoning, namely, those that produce an enterotoxin. Enterotoxigenic strains of S. aureus produce six different enterotoxins: A, B, C, D, E, F etc which are serologically distinct heat stable proteins of molecular weight of 26 to 30 kDa. Staph toxins are enteric toxins and cause gastroenteritis. About 30 g or ml of food containing toxins produced by 106 to 107 cells per gram (ml) for a normal healthy individual is sufficient to cause the symptoms. The primary symptoms are salivation, nausea and vomiting, abdominal cramps & diarrhea. Secondary symptoms are sweating, chills, headache and dehydration.
Identification methods
Enumeration technique in one or more selective differential media like Baird-Parker agar and G.C. Gioletti Cantoni broth to determine the load of viable cells followed by several biochemical tests, such as hemolysis, coagulase, thermonuclease reactions are performed to link the potential cause of food poisoning outbreaks. Sensitive immunological tests viz., ELISA etc has been developed for this purpose.
2) Botulism
Although the disease is very rare, the disease has a high fatality rate. Botulism is caused by the bacterium Clostridium botulinum, which produces an exotoxin that is most potent of all known
poisons. 1 gram is sufficient to kill approximately 30 billion mice.
Biology of Clostridium botulinum
Clostridium botulinum is an anaerobic, Gram-positive, spore-forming rod that produces a potent neurotoxin (Fig. 4). Spores of C. botulinum are widely distributed in soil, sewage, mud, sediments of marshes, lakes and coastal waters, plants- fruits and vegetables and intestinal contents of animals and fishes. Cells are sensitive to low pH (<4.6), lower Aw (0.93), and moderately high salt (5.5%). The spores are heat-resistant (killed at 1150C) and can survive in foods that are incorrectly or minimally processed. Spores do not germinate in the presence of nitrate (250 ppm). Foods most commonly associated are low acid vegetables (green beans, corn, spinach, asparagus, pepper and mushrooms) and fruits (figs and peaches) and also fermented, improperly cooked and smoked fish, meat, poultry and fish eggs in hermatically sealed containers.
Toxins, Disease and Symptoms
Seven types (A, B, C, D, E, F and G) of botulism are recognized, based on the antigenic specificity of the neurotoxin produced by each strain. Types A, B, E and F cause human botulism. Types C and D cause most cases of botulism in animals. As they are highly potent toxins only a very small amount (1ng/kg body weight) is necessary for severe symptoms and even death. The toxins are heat labile and can be destroyed by high and uniform heat- 950C for 15 minutes or boiling for 5 minutes.
At the initial stage (generally 12h to 36h, but can be 2h), some gastrointestinal symptoms (nausea, vomiting, diarrhea and constipation) are evident. Neurological symptoms appear in a short time particularly when the amount of toxin consumed is more, which includes blurred or double vision, difficulty in swallowing, breathing and speaking, dryness of the mouth, and paralysis of different involuntary muscles that spreads to the lung and heart. Death usually results from respiratory failure.
Identification methods
The presence of C. botulinum can be determined by enumeration techniques using selective agar media and followed by anaerobic incubation. The presence of toxins is more often tested by immunological methods like ELISA etc.
3) Salmonella Gastroenteritis
Before 1940s, Salmonella typhi and S. paratyphi were considered the major causes of worldwide foodborne and waterborne diseases caused by Salmonella. With the introduction of pasteurization of milk and chlorination of water supplies, the spread of typhoid and paratyphoid fever was greatly reduced. However, the incidence of foodborne cases of Salmonellosis is still on the rise, which is quite puzzling. This may be attributed to various reasons: the increase in number of antibiotic resistant Salmonella isolates, increase in number of HIV cases which are

Fig. 4: Clostridium botulinum cells more sensitive to Salmonella, the increase in number of egg-associated S. enteritidis contamination, and food production in centralized facilities, leading to large and widespread outbreaks incase contamination occurs.
Biology of Salmonella
Salmonella is a rod-shaped, Gram negative, non-sporulating, facultative anaerobic motile bacterium. They are mesophiles with a growth temperature range of 5 to 460C and optimum growth temperature of 35 to 370C. They are sensitive to low aW (<0.94) and low pH (4.5 or below). There are over 2000 serovars of Salmonella based on flagellar, somatic and capsular antigens, which are capable of causing Salmonellosis in humans. Salmonella are natural inhabitants of gastrointestinal tracts of animals, birds, pets, frogs, turtle and insects. They are also present in soil, water and sewage contaminated with fecal matter from where they can contaminate foods directly or indirectly and can cause Salmonellosis. Foods generally associated with outbreaks of Salmonella includes raw meats, poultry, eggs, milk and dairy products, fish, shrimp, frog legs, yeast, coconut, sauces and salad dressing, cake mixes, cream- filled desserts and toppings, dried gelatin, peanut butter, cocoa, and chocolate. Various Salmonella species have long been isolated from the outside of egg shells.
Toxins, Disease and Symptoms
Generally 105 to 106 cells need to be consumed for food borne salmonellosis but it can be as few as 15- 20 cell in some cases. The disease starts with the penetration and passage of Salmonella organisms from gut lumen into epithelium of small intestine where inflammation occurs; there is evidence that an enterotoxin may be produced, perhaps within the enterocyte. S. typhi and the paratyphoid bacteria normally cause septicemia and produce typhoid or typhoid-like fever in humans. Other forms of salmonellosis generally produce milder symptoms which includes nausea, vomiting, abdominal cramps, diarrhea, chills, fever, headache and prostration.
Identification methods
The identification & enumeration of Salmonella can be done using selective differential agar media (Fig. 5). Although conventional culture methods require 5 days for presumptive results, several rapid methods are available which require only 2 days. Immunological methods which are used to detect Salmonella include ELISA, enrichment serology and Fluorescent Antibody technique. Recently, PCR and Real Time PCR based methods employing specific base sequence of the DNA have been developed which can detect the organism in about 5 hours e.g, Qualicons BAX system and Gene Trak Systems.
4) Shigellosis (Bacillary Dysentery)
The genus Shigella contains four species: Shigella dysenteriae, Sh. flexneri. Sh. boydii, and Sh. sonnei and each species have several serovars. Children below 5 years of age are most affected.
Biology of Shigella
Shigella is Gram-negative, non-motile, non-spore forming rod-shaped bacteria. The strains grow between 7 and 460C, with an optimum at 370C. They can survive for days under refrigeration, freezing, and 5% NaCl and pH4.5, but are sensitive to pasteurization. The organism is frequently found in water polluted with human feces. The foods implicated in outbreaks include salads, raw vegetables, milk and dairy products, and poultry. Contamination of these foods is usually through the fecal-oral route. Fecal contaminated water and unsanitary handling by food handlers are the most common causes of contamination.
Fig. 5: Differential media used for identification. A) Growth of Salmonella on Blood agar; B) Growth of Salmonella on Chromogenic Salmonella Esterase Agar; C) Green colonies of Salmonella on Hektoen Enteric (HE) agar; D) Bright orange colonies of Enterobacter on HE agar; E) Bright pink of E.coli on MacConkey agar plates; F) Growth of E. coli on EMB agar
Fig. 5: Differential media used for identification. A) Growth of Salmonella on Blood agar; B) Growth of Salmonella on Chromogenic Salmonella Esterase Agar; C) Green colonies of Salmonella on Hektoen Enteric (HE) agar; D) Bright orange colonies of Enterobacter on HE agar; E) Bright pink of E.coli on MacConkey agar plates; F) Growth of E. coli on EMB agar
Toxins, Disease and Symptoms
The strains are believed to produce a plasmid encoded invasive factor-Shiga toxin, which is an exotoxin having enterotoxigenic property. The infective dose is very low as few as 10 cells depending on age and condition of host. The symptoms include abdominal pain, cramps, diarrhea, fever, vomiting, accompanied by blood, pus, or mucus in the stools. Infections are associated with mucosal ulceration, rectal bleeding, drastic dehydration; fatality may be as high as 10-15% with some strains.
Identification methods
Organisms are difficult to demonstrate in foods because methods are not developed or are insensitive. A genetic probe to the virulence plasmid has been developed by FDA and is currently under field test. However, the isolation procedures are still poor.
5) Escherichia coli enteritis
Since its discovery in 1805, E. coli was considered a harmless, Gram negative, motile, non- sporulating; rod shaped, facultative anaerobic bacterium, a normal inhabitant of Gastro-intestinal Tract (GIT) of humans and warm blooded animals and birds. As it is present in high number in intestine, it has been used as an indicator organism of possible fecal contamination of enteric pathogens in foods and water. Since in mid 1940s, evidence has accumulated that certain E. coli strains cause diarrhea, particularly in infants, and they were then designated as pathogens. The four groups of pathogenic E. coli are:
i) Enterotoxigenic Escherichia coli (ETEC)
Disease
Gastroenteritis/ travelers' diarrhea are the common name of the illness caused by ETEC.
Infective dose
A relatively large dose (100 million to 10 billion bacteria) of ETEC is probably necessary to establish colonization of the small intestine, where these organisms proliferate and produce toxins which induce fluid secretion.
Symptoms
The most frequent clinical syndrome of infection includes watery diarrhea, abdominal cramps, low-grade fever, nausea and malaise.
Associated food
Contamination of water with human sewage may lead to contamination of foods. Infected food handlers may also contaminate foods. These organisms are infrequently isolated from dairy products such as semi-soft cheeses.
Identification methods
With the availability of a gene probe method, foods can be analyzed directly for the presence of ETEC, and the analysis can be completed in about 3 days. Alternative methods which involve enrichment and plating of samples for isolation of E. coli and their subsequent confirmation as toxigenic strains by conventional toxin assays may take at least 7 days.
ii) Enteropathogenic Escherichia coli (EPEC)
Disease
Infantile diarrhea is the name of the disease usually associated with EPEC.
Infective dose
EPEC are highly infectious for infants and the dose is presumably very low. In the few documented cases of adult diseases, the dose is presumably similar to other colonizers (> 106 total dose).
Symptoms
Occasionally, diarrhea in infants is prolonged, leading to dehydration, electrolyte imbalance and death (50% mortality rates have been reported in third world countries).
Associated food
Common foods implicated in EPEC outbreaks are raw beef and chicken, although any food exposed to fecal contamination is strongly suspect.
Identification methods
The isolation and identification of E. coli in foods follows standard enrichment and biochemical / immunological procedures.
iii) Enterohemorrhagic E. coli (EHEC)
Disease
Hemorrhagic colitis is the name of the acute disease caused by E. coli O157:H7.
Infective dose
Unknown, but may be similar to that of Shigella spp. (as few as 10 organisms).
Symptoms
The illness is characterized by severe cramping (abdominal pain) and diarrhea which is initially watery but becomes grossly bloody. Occasionally vomiting occurs. Fever is either low-grade or absent.
Associated food
Undercooked or raw hamburger (ground beef) has been implicated in many of the documented outbreaks, however E. coli O157:H7 outbreaks have implicated unpasteurized fruit juices, dry- cured salami, lettuce, game meat, and cheese curds.
Identification methods
Several microbiological methods can be used to isolate E. coli O157:H7 from foods. Sorbitol- MacConkey agar has been used extensively to isolate this organism from clinical specimens. Hemorrhagic colitis agar, a selective and differential medium, is used in a direct plating method to isolate O157:H7 from foods. Rapid methods using a variety of technologies, including recombinant DNA methods, are being developed.
iv) Enteroinvasive Escherichia coli (EIEC)
Disease
Enteroinvasive E. coli (EIEC) may produce an illness known as bacillary dysentery. Following the ingestion of EIEC, the organisms invade the epithelial cells of the intestine, resulting in a mild form of dysentery, often mistaken for dysentery caused by Shigella species.
Infective dose
The infectious dose of EIEC is thought to be as few as 10 organisms (same as Shigella).
Symptoms
The illness is characterized by the appearance of blood and mucus in the stools of infected individuals, abdominal cramps, diarrhea, vomiting, fever, chills, and a generalized malaise.
Associated food
It is currently unknown what foods may harbor EIEC, but any food contaminated with human feces from an ill individual, either directly or via contaminated water, could cause disease in others.
Identification methods
Foods are examined as are stool cultures. Detection of this organism in foods is extremely difficult because undetectable levels may cause illness.
6) Bacillus cereus Gastroenteritis
The causal organism is a bacterium Bacillus cereus, which is a Gram-positive, facultative aerobic spore former whose cells are large rods and whose spores do not swell the sporangium situated centrally or sub-terminally. A wide variety of foods including meats, milk, vegetables, and fish have been associated with the diarrheal type food poisoning. The vomiting-type outbreaks have generally been associated with rice products; however, other starchy foods such as potato, pasta and cheese products have also been implicated.
Toxins, Disease and Symptoms
The presence of large numbers of B. cereus (> 106 organisms/g) in a food is indicative of active growth and proliferation of the organism and is consistent with a potential hazard to health. B. cereus food poisoning is the general description, although two recognized types of illness are caused by two distinct metabolites. The diarrheal type of illness is caused by a large molecular weight protein, while the vomiting (emetic) type of illness is believed to be caused by a low molecular weight, heat-stable peptide. The symptoms of B. cereus diarrheal type food poisoning are the onset of watery diarrhea, abdominal cramps, and pain after 6-15 hours of consumption of contaminated food. Nausea may accompany diarrhea, but vomiting (emesis) rarely occurs. The emetic type of food poisoning is characterized by nausea and vomiting within 0.5 to 6 h after consumption of contaminated foods. Occasionally, abdominal cramps and/or diarrhea may also occur.
Identification methods
B. cereus can be enumerated by surface plating on a mannitol, egg yolk agar medium with polymyxin B as the selective medium. Colonies surrounded by precipitation resulting from lecithinase are indicative of B. cereus.
7) Yersinia enterocolitica Gastroenteritis
Foodborne yersiniosis was first confirmed in USA in 1976 following an outbreak involving large number of school children upon consumption of chocolate milk contaminated with Yersinia enterocolitica. In Denmark, food borne yersiniosis is one of the most common forms of Gastroenteritis.
Biology of Yersinia enterocolitica
Y. enterocolitica is a psychrotrophic small rod-shaped, non spore forming, motile, facultative anaerobic gram-negative bacterium. Strains of Y. enterocolitica can be found in meats (pork, beef, lamb, etc.), oysters, fish, and raw milk. The strains can grow between 0 and 440C temperature, 5% NaCl and at a pH above 4.6.
Toxins, Disease and Symptoms
Yersiniosis is the disease caused by Y. enterocolitica. Young children are more succeptible to food borne Yersiniosis. Yersinia infections mimic appendicitis, but the bacteria may also cause infections of other sites such as wounds, joints and the urinary tract. Infective dose is unknown. Illness onset is usually between 24 and 48 hours after ingestion and is frequently characterized by symptoms such as gastroenteritis with diarrhea and/or vomiting; however, fever and abdominal pain are the hallmark symptoms.
Identification methods
The isolation method is relatively easy to perform, but in some instances, cold enrichment may be required. Y. enterocolitica can be presumptively identified in 36-48 hours. However, confirmation may take 14-21 days or more. Determination of pathogenicity is more complex.
8) Listeriosis by Listeria monocytogenes
Human listeriosis, caused by Listeria monocytogenes has been recognized for long time. The species has many serovars, namely, 1/2a, 1/2b, 1/2c, 3a, 3b, 3c and 4b. This is a Gram-positive, psychrotrophic, facultative, non-sporulating, motile small rod. L. monocytogenes is quite hardy and resists the deleterious effects of freezing, drying, and heat remarkably well for a bacterium that does not form spores. L. monocytogenes has been associated with such foods as raw milk, supposedly pasteurized fluid milk, cheeses (particularly soft-ripened varieties), ice cream, raw vegetables, fermented raw-meat sausages, raw and cooked poultry, raw meats (all types), and raw and smoked fish. Its ability to grow at temperatures as low as 3°C permits multiplication in refrigerated foods.
Toxins, Disease and Symptoms
Listeriosis is the name of the general group of disorders caused by L. monocytogenes. The infective dose of L. monocytogenes is unknown but is believed to vary with the strain and susceptibility of the victim. The sensitive group includes pregnant women, unborn fetuses, infants, elderly people and immuno-compromised people. The virulence factor identified is a specific type of hemolysin, listeriolysin O which is produced during active growth. The manifestations of listeriosis include septicemia, meningitis (or meningoencephalitis), encephalitis, and intrauterine or cervical infections in pregnant women, which may result in spontaneous abortion (2nd/3rd trimester) or stillbirth. The onset of the aforementioned disorders is usually preceded by influenza-like symptoms including persistent fever. It was reported that gastrointestinal symptoms such as nausea, vomiting, and diarrhea may precede more serious forms of listeriosis or may be the only symptoms expressed.
Identification methods
The methods for analysis of food are complex and time consuming. The present FDA method requires 24 and 48 hours of enrichment, followed by biochemical or immunological tests. Total time to identification is from 5 to 7 days, but the use of specific non-radiolabled DNA probes involving listeriolysin O gene have led to a simpler and faster confirmation of suspect isolates e.g., BAX system.
9) Campylobacter Enteritidis/ Campylobacteriosis
Campylobacteriosis caused by C. jejuni was first recognized as the cause of an outbreak in 1979. It is also often known as campylobacter enteritis or gastroenteritis. It is caused by several species of Campylobacter, however Campylobacter jejuni and Campylobacter coli are more common. Campylobacter jejuni is a Gram-negative slender, curved, and motile rod. It is a microaerophilic organism, which means it has a requirement for reduced levels of oxygen. It is relatively fragile, and sensitive to environmental stresses (e.g., 21% oxygen, drying, heating, disinfectants, acidic conditions). C. jejuni frequently contaminates raw chicken. Raw milk is also a source of infections. The bacteria are often carried by healthy cattle and by flies on farms. Non-chlorinated water may also be a source of infections. However, properly cooking chicken, pasteurizing milk, and chlorinating drinking water will kill the bacteria. It is considered as one of the most frequent cause of food infection next to salmonella.
Toxins, Disease and Symptoms
C. jejuni produces thermolabile enterotoxins that cross reacts with cholera toxin. The infective dose of C. jejuni is about 400-500 bacteria. C. jejuni infection causes diarrhea, which may be watery or sticky and can contain blood (usually occult) and fecal leukocytes (white cells). Other symptoms often present are fever, abdominal pain, nausea, headache and muscular pain.
Identification methods
The identification methods require an enrichment broth containing antibiotics, special antibiotic- containing plates and a microaerophilic atmosphere generally a microaerophilic atmosphere with 5% oxygen and an elevated concentration of carbon dioxide (10%). Isolation can take several days to a week.
10) Vibrio species
Two species of Vibrio which are of prime concern and are emerging as food borne pathogens are:
A. Vibrio parahemolyticus Gastroenteritis
Gastroenteritis caused by Vibrio parahemolyticus is quite common in Japan and accounts for 40 to 70% for the total foodborne poisonings. The cells are Gram-negative, non-sporulating motile curved rods with an optimum temperature of 30 to 370C, but can grow over a temperature range of 5 and 420C. The cells can grow quickly in a salt concentration of 3 to 5% NaCl but are sensitive to 10% salt. This bacterium is frequently isolated from the estuarine and marine environment of the United States. Both pathogenic and non-pathogenic forms of the organism can be isolated from marine and estuarine environments and from fish and shellfish dwelling in these environments. Infections with this organism have been associated with the consumption of raw, improperly cooked, or cooked, recontaminated fish and shellfish. Improper refrigeration of seafood contaminated with this organism will allow its proliferation, which increases the possibility of infection.
Toxins, Disease and Symptoms
V. parahemolyticus associated gastroenteritis is the name of the infection caused by this organism. The pathogenic strains are capable of producing a heat-stable hemolysin factor and are designated as Kangawa positive. Disease is caused when the organism attaches itself to an individuals' small intestine and excretes an heat stable hemolysin factor. A total dose of greater than one million organisms may cause disease. Diarrhea, abdominal cramps, nausea, vomiting, headache, fever, and chills may be associated with infections caused by this organism. The illness is usually mild or moderate, although some cases may require hospitalization.
B. Vibrio vulnificus Septicemia
Vibrio vulnificus, a lactose-fermenting, halophilic, gram-negative, opportunistic pathogen, is found in estuarine environments and associated with various marine species such as plankton, shellfish (oysters, clams, and crabs), and finfish. Consumption of these products raw or recontaminated may result in illness.
Toxins, Disease and Symptoms
This organism causes wound infections, gastroenteritis, or a syndrome known as "primary septicemia". The infective dose for gastrointestinal symptoms in healthy individuals is unknown but for predisposed persons, septicemia can presumably occur with doses of less than 100 total organisms. The ingestion of V. vulnificus by healthy individuals can result in gastroenteritis. The "primary septicemia" form of the disease follows consumption of raw seafood containing the organism by individuals with underlying chronic disease, particularly liver disease. It may also cause distinctive bulbous skin lesions.
General Control Measures for Prevention of Food Borne Diseases
- a) By employing proper sanitary measures.
- b) By the use of chemical agents in preventing the growth of microorganisms.
- c) Removing left over food promptly from work surfaces and utensils in food preparation area.
- d) By cooking or applying proper and desired processing treatment to the food before consumption.
- e) By avoiding chances of re-contamination of food, hence storing it in proper package.
- f) Maintaining good personal hygiene, like food handlers should not have any open cuts and wounds.
- g) Maintaining proper sanitation and preventing contamination of water to be used.
- h) Use of proper storage condition restricting recontamination and growth.
Microbial Testing of Foods
The examination of foods for the presence of microorganisms is one of the important areas of food microbiology. Number of bacteria in foods is an indicator of their handling, processing and ultimately quality. The various types of methods used can be grouped broadly into two classes: Conventional methods and Rapid methods. The conventional methods include cultural and microscopic methods, physical methods, chemical methods and the immunological methods, while the rapid methods includes the use of DNA based methods.
Conventional Methods
a) Cultural and microscopic methods
The four basic type of methods included in this category are:
Standard Plate Count (SPC)
SPC is useful in determining the viable number of microorganisms in foods. The procedure consists of diluting the organisms in a series of sterile dilution blanks. From blanks, measured amounts of diluted organism are transferred by spread plating/ pour plating over the appropriate agar plates and incubated for 24-48 h. Thereafter plates are examined and number of colonies is counted to calculate the number of viable cells or colony forming units per unit volume of material under test. The counts obtained in this method depend on some factors: nature of food flora and material, plating medium used, pH, aW and Eh of the medium, type of diluents and temperature of incubation. The disadvantages of the method are that the technique is cumbersome, material intensive and time consuming.
Most Probable Number (MPN)
The method was introduced by McCrady in 1915. This is a qualitative method for determination of the presence of coliforms in potable water. The selective medium used is MacConkey’s medium which contains a bile salt inhibitory for growth of non-intestinal lactose fermenting bacteria. Since the method is statistical in nature, MPN results are generally higher than SPC. The test can be performed in two formats- three tube and five tube method. The advantages of the method are as follows:
- it is a simple technique
- good agreement between results from different laboratories;
- identification of specific microbial group is possible by the use of appropriate selective and differential medium.
Among the disadvantages is the requirement for large number of glass wares and lack of precision.
Dye reduction Method (MBRT)
Dye reduction test involve the use of redox dyes like methylene blue to determine the quality of milk. Methylene blue is reduced and loses its color in the presence of actively growing bacteria. The time taken for the reduction of methylene blue is inversely proportional to the number of viable bacteria. The shorter the methylene blue reduction time poorer is the quality of the milk. The advantages of the method are as follows:
- It is a simple and rapid method for grading bulk supplies of raw milk;
- It is an inexpensive method;
- No skilled personnel are needed to perform the test.
Disadvantages of the test are it does not indicate the type and source of organism and variations in the degree of bacterial metabolism.
Direct Microscopic count (DMC)
Another quick and precise method for determination of microorganisms in liquid foods is the use of haemocytometer or Neubauer counting chamber. The method is quick and requires expertisation. In the method appropriately diluted samples are transferred on the haemocytometer using a Pasteur pipette and counted directly under the microscope. The haemocytometer is itched with a grid system into number of squares (25 large squares). The number of microorganisms present in the large square are counted and multiplied with the factor for large square and dilution factor to determine the total number of microorganisms in the sample. Among the advantages of DMC are: it is rapid and simple and cell morphology can be assessed. Among its disadvantages are: it is microscopic method and therefore fatiguing to the analyst; both viable and nonviable cells are enumerated; food particles interfere with the microbial counts; and DMC counts are invariably higher than counts by SPC.
b) Physical Methods
Impedance
Impedance is the apparent resistance in an electric circuit to the flow of alternating current corresponding to the actual electrical resistance to a direct current. When microorganisms grow in culture media, they metabolize substrates of low conductivity into products of higher conductivity and thus decrease the impedance of the media. When the impedance of broth cultures is measured, the curves are reproducible for species and strains, and mixed cultures can be identified by use of specific growth inhibitors. The technique is capable of detecting as low as ten to one hundred cells. Cell populations of 105-106/ml can be detected in 3-5 h; and 104-105/ml in 5-7 h. The times noted are required for the organisms to attain a threshold of 106-107 cells/ml.
Impedance has been widely used to monitor the overall microbial quality of various foods like pureed vegetables, cream pies, raw milk, ground meat, and other foods. Also, it is a rapid method to detect coliforms and fecal coliforms in meats. The method can also be used to predict shelf life of pasteurized milk and detection of spoilage organisms in beer fermentation. Yeasts growing in wort caused an increase in impedance while bacteria caused a decrease. Impedance can be used to classify frozen orange juice concentrate as acceptable or unacceptable and has been employed to detect starter culture failure within 2h. In general, impedance methods measure changes with the conductance of the growth medium. Conductance generally increases from 10 to 100% during growth, apparently from the increase in ion pairs as a result of metabolic activity.
Microcalorimetry
Microcalorimetry is the measurement of small heat changes involved in the breakdown of growth substrates. The measured heat production is closely related to the cell’s catabolic activities. There are two types of calorimeters - batch and flow. One of the most commonly used microcalorimeters is the Calvet instrument, which is sensitive to a heat flow of 0.01 cal/h from a 10-ml sample.
It is a rapid method for identification and characterization of food-borne organisms, but results vary according to the history of the organism, inoculum size and fermentable substrates. Microcalorimetry has been used to the study of spoilage in canned foods, to differentiate between the Enterobacteriaceae, to detect the presence of Staphylococcus aureus, and to estimate bacteria in ground meat.
Flow cytometry
Flow cytometry is the science of measuring components and the properties such as fluorescence, absorbance and light scatter of individual cells in liquid suspension. In this method, suspended cells are brought one by one to a detector by means of a flow channel using cell sorters. Fluidic devices under laminar flow define the trajectories and velocities that cells traverse the detector and measure the cell properties. Flow cytometers and cell sorters make use of one or more excitation sources such as argon, krypton, or helium-neon ion lasers, and one or two fluorescent dyes to measure and characterize several thousand cells/sec.
The application of flow cytometry in the analysis of foods for their microbial content was suggested by Van Dilla et al.,1983 in which bacteria were stained with fluorescent dyes one of which bound preferentially to DNA rich in guanine-cytosine while the other bound to adenine- thymine rich DNA. Thus, the rapid identification of bacteria in food based upon their specific A- T/G-C ratios is possible. The method can also be used to distinguish between living and dead cells by dual staining; to determine the ploidy of yeast cells; to differentiate between spores and vegetative cells in Bacillus spp; and to separate pathogenic and non-pathogenic amoebae.
c) Chemical methods
Thermostable nuclease
This method can be used to detect the presence of S. aureus in foods. This is possible because of the high correlation (95%) between the production of coagulase and thermostable nuclease by enterotoxin producing S. aureus strains. The method is a spectrophotometric method and the amount of extractable thermostable nuclease increases with the numbers of cells in foods. The advantages of testing for heat stable nuclease as an indicator of S. aureus growth and activity includes:
- because of its heat stable nature, the enzyme will persist even if the bacterial cells are destroyed by heat, chemicals, or bacteriophage, or if they are induced to L-forms;
- the heat-stable nuclease can be detected faster than enterotoxin (about 3 h versus several days),
- the nuclease appears to be produced by enterotoxigenic cells before enterotoxins appear;
- the nuclease is detectable in unconcentrated cultures of food specimen while enterotoxin detection requires concentrated samples; and
- the nuclease of concern is stable to heat as are the enterotoxins.
There is high correlation between coagulase positive enterotoxigenic strain and thermostable nuclease producing strain.
Limulus lysate for endotoxins
Gram negative bacteria are characterized by their production of endotoxins which consists of LPS layer of the cell envelope. The Limulus amoebocyte lysate (LAL) test employs a lysate protein obtained from the blood cells of the horseshoe crab. The lysate protein is the most sensitive substance known for endotoxins (3-300 times more sensitive to endotoxins than the U.S. Pharmacopeia rabbit pyrogen test). The LAL test is performed by adding aliquots of food suspensions or other test materials to small quantities of a lysate preparation followed by incubation at 37°C for 1 h. The presence of endotoxins caused gel formation of the lysate material.
The LAL test has been found to be suitable for the rapid evaluation of the hygienic quality of milk relative to the detection of coliforms before and after pasteurization. Since both viable and nonviable gram-negative bacteria are detected by LAL, simultaneous plating is necessary to determine the numbers of cfu’s. The method has been applied successfully to detect the microbial spoilage of ground beef; to monitor milk and milk products; microbial quality of raw fish; and cooked turkey rolls.
ATP Measurement
Adenosine-triphosphate (ATP) is the primary source of energy in all living organisms. It disappears within 2 h after cell death and the amount per cell is generally constant, with values around 4 x 104 M ATP/105 cfu of bacteria. One of the simplest ways to measure ATP is by use of the firefly luciferin-luciferase system. In the presence of ATP, luciferase emits light, which is measured with a liquid scintillation spectrometer / luminometer. The amount of light produced by firefly luciferase is directly proportional to the amount of ATP added.
This is a rapid method for assessing biomass in activated sludge and estimation of microorganisms in foods. The major problem that has to be overcome for food use is the removal of nonmicrobial ATP and other problems like one yeast strain was found to contain 300 times more ATP than the average for bacterial cells.
Radiometry
This method is based upon the incorporation of a 14C-labeled metabolite in a growth medium (14C formate, 14C glucose, 14C glutamate) so that when the organisms utilize this metabolite, 14CO2 is released and measured by use of a radioactivity counter. In this method, 10ml of medium containing labeled metabolite in a serum vial is inoculated with suspected sample. Following incubation, the headspace is tested periodically for the presence of 14CO2. The time required to detect the labeled CO2is inversely related to the number of organisms in a product.
This method can be used for detection of coliforms in water and sewage; for detection of S. aureus, S. typhimurium, and spores of Clostridium botulinum in beefs; for detection of organisms in frozen orange juice concentrate.
Glucuronidase assay for E. coli
The enzyme β-glucuronidase (GUD) is produced by 97% of E.coli strains and upto 50% of salmonellae and shigellae. In the presence of the substrate 4-methylumberlliferone-β-D- glucuronide (MUG), GUD produces a fluorogenic end product which is visible in UV light.
Thus, it is a rapid and more efficient way to detect E.coli in foods; one E.coli cell could be detected in 20 h. While most positive reactions occurred in 4 h, some weak GUD-positive strains required up to 16 h for reaction. The main advantage of this method is that fluorescence appears before gas production from lactose. Also, some salmonellae and shigellae are GUD positive does not invalidate the method since these organisms are of greater significance in foods than coliforms.
d) Immunological Methods
Fluorescent antibody
In this technique, an antibody to a given antigen is made fluorescent by coupling it to a fluorescent compound such as rhodamine b, fluorescein isocyanate, and fluorescein isothiocyanate, and when the antibody reacts with its antigen, the antigen-antibody complex emits fluorescence that can be detected using fluorescent microscope. The application of FA to the examination of foods for detection of salmonellae is made after cultural enrichment procedures have been carried out. The technique can be used to detect salmonellae in milk and large number of different types of foods and related products. The procedure has been used also to monitor food-processing plant, utensils and equipments.
In addition to salmonellae, FA can be used to identify clostridia including C. perfringens and C. botulinum. The advantages of this method includes: (1) FA is more sensitive and rapid method (18-24h) than cultural methods; (2) reduction in time for negative tests on food products makes it possible to free foods earlier for distribution (3) larger numbers of samples can be analyzed, making for increased sampling of food products; and (4) the qualitative determination of specific salmonellae serotypes is possible for FA if desired for epidemiologic reason.
Enrichment serology
Enrichment serology is a more rapid method for identification and isolation of salmonellae from foods than the conventional cultural methods. It is carried out in four steps : (1) pre-enrichment in a nonselective medium for 18h; (2) selective enrichment in selenite-cystine and/or tetrathionate broth for 24h; (3) selective enrichment in M broth for either 6-8 h ; and (4) agglutination with polyvalent H antisera at 50°C for 1 h. Results can be obtained in 50 h compared to 96-120 h by CCM for dried foods and feeds. ES results are comparable with FA. Possible disadvantage to its use is the cells/ml and its lack of response to nonmotile salmonellae.
Radioimmunoassay (RIA)
This technique consists of adding a radioactive label to an antigen, allowing the labeled antigen to react with its specific antibody, and measuring the amount of antigen that combined with the antibody by use of a radioactivity counter. In solid-phase RIA, antibody molecules are immobilized on the solid surfaces like polypropylene, polystyrene, bromacetylcellulose etc. The antibody-coated polymers bind specifically with radioactive tracer antigens. Upon washing, the free-labeled antigen is washed out, and the radioactivity measurements are quantitative. The label used commonly is [125]I.
RIA can be used for determination of S. aureus enterotoxin B and the test was quantitatively reliable at an enterotoxin level of 0.01 μg/ml. A RIA method has also been developed for E. coli ST that detected 50 to 500 pg toxin/tube. The RIA technique lends itself to the examination of foods for other biological hazards such as endotoxins, paralytic shellfish toxins, and the mycotoxins like Ochratoxin A and Aflatoxin M1 (AFM1).ELISA
The enzyme-linked immunosorbent assay (ELISA, enzyme immunoassay, or EIA) is an immunological method similar to RIA but employs an enzyme coupled to antigen or antibody rather than a radioactive isotope. A typical ELISA is performed with antiserum. Following incubation and washing, an enzyme-labeled preparation of anti-immunoglobulin is added. After gentle washing, the enzyme remaining in the tube or microtiter well is assayed to determine the amount of specific antibodies in the initial serum. A commonly used enzyme is horseradish peroxidase or alkaline phosphatase, and its presence is measured by the addition of peroxidase substrate- OPD. Variations of this basic ELISA consist of a “sandwich” ELISA in which the antigen is required to have at least two binding sites. Among the applications of the ELISA technique in food microbiology is its use to detect Staphylococcal enterotoxins, botulinal toxins, salmonellae, shigellae, mycotoxins, viruses, toxoplasma antibodies, and antibodies to gram- negative endotoxins.
Rapid Detection of Emerging High Risk Pathogens in Foods
Recent advances in biotechnology have considerably simplified microbiological procedures for detection of pathogens and have reduced the assay time. Table 14 shows the comparison between the conventional versus recent methods for detection of microbial pathogens in foods. These assay procedures include use of DNA probes and PCR based tests.
Table 14: Conventional versus recent methods for detection of microbial pathogens in foods
| Conventional methods For pathogen identification | Cultivation and characterization of organism in laboratory, Detection of host immune response (e.g., antibodies) to known organism. Visual detection of "typical" microbial form in host. |
Problems with conventional methods | Cultivation-based methods insensitive for detecting some organisms. Conventional methods limited to pathogens with known growth requirements. Temperature of incubation used not conducive for all types of organisms. |
Examples of failures with conventional approaches | Detection of slow-growing organisms takes weeks. |
New molecular methods | Use of genetic (DNA or RNA) sequences to identify micro organisms plus DNA amplification procedures (e.g., polymerase chain reaction, PCR) leads to development of specific and consensus PCR methods. Other experimental sequence-based molecular methods for detection of novel microorganisms (e.g., "representation difference analysis"). |
Advantages | Rapid, specific & sensitive. |
Future applications | Rapid, automated identification of known microbial pathogens on routine basis. More rapid and sensitive detection and identification of emerging, novel microbial pathogens |
DNA probe based detection systems
A DNA probe is a short (14-40 bases) single-stranded sequence of nucleotide bases that will bind to specific regions of single-stranded target DNA sequences; the homology between the target and the DNA probe results in stable hybridization. Hybridization is monitored by labelling probes, by attachment to or incorporation into the probe, with compounds that can be detected visually or chemically. Isotopes such as 32P can be incorporated into the structure of the probe.
Enzymes such as alkaline phosphatase or horseradish peroxidase (HRP) are often linked to the probe via a chemical linkage; hybridization can be detected visually following addition of substrates. Fluorescently labelled compounds such as fluorescein isothiocyanate can also be attached directly to probes. Some of the examples of DNA probes used for the detection of food borne pathogens are provided in Table 15.
Table 15: DNA probes for food borne pathogens
| Food borne pathogen | Component detected | Labelling system |
|---|---|---|
Salmonella spp. Listeria spp. Listeria monocytogenes Escherichia coli Yersinia enterocolitica Vibrio vulnificus Campylobacter spp. Staphylococcus aureus Shigella spp. | Chromosomal DNA fragment 23S rRNA 16S rRNA | Isotopic Isotopic 32P |
PCR- based detection of food pathogens
Polymerase Chain Reaction (PCR) has recently emerged as the most powerful molecular technique in the area of diagnostics. It is now being increasingly used for monitoring of foods for potential food pathogens, so that the safety of these foods could be ensured from public health point of view. Using PCR, the target DNA sequence can be selectively amplified, thus increasing the amount of target available for detection. The PCR technique is based on the reiteration of three-step process : denaturation of dsDNA into single strands, annealing extension primers homologous to the target DNA sequence to be amplified to the single stranded DNA, and enzymatic extension of primers using a thermostable enzyme such as Taq DNA polymerase, as illustrated in Fig. 6. A typical amplification is 20-40 cycles and results in million fold amplification of the original target DNA. The DNA from the single cell would be detectable following PCR amplification. Application of such methods in Food Quality Assurance and Public Health Labs can go a long way in protecting the health of the public. The crucial feature of sample preparation in the direct analysis of food without cultural enrichment is the isolation of target DNA with high reproducibility and efficiency. Construction of the actual PCR assay requires nucleotide sequence information and knowledge about the chosen target gene to guarantee maximum specificity and sensitivity. By using different formats of PCR, it is now possible to simultaneously detect more than one food pathogen in the food. PCR-based detection of food pathogens has completely revolutionized the area of diagnostics as the results are available in less than 24 h to enable the food processing units to take appropriate follow up action if a pathogen is detected in a food to avoid any risk to the consumers.

Fig. 6: DNA amplification using polymerase chain reaction
Nucleic acid based assays are supposed to the exquisitively sensitive and reliable as the genome of the organism is responsible for the expression of biochemical or serological characteristics of the target organisms. Rapid test kits which rely on the interaction of nucleic acid probes with the conserved or marker sequence of target nucleic acids have been developed, some examples of which are indicated in Table 16. Virulence associated genes are commonly targeted for the detection of pathogens in foods. Two types of nucleic acid probe-based tests (colorimetric and chemiluminescent) are available for Salmonella, E. coli, Yersinia enterocolitica and Listeria.
Real-Time Vs Traditional PCR
Real-Time chemistries allow for the detection of PCR amplification during the early phases of the reaction. Measuring the kinetics of the reaction in the early phases of PCR provides a distinct advantage over traditional PCR detection. Traditional methods use agarose gels for detection of PCR amplification at the final phase or end-point of the PCR reaction (Fig. 7)
Limitations of End-Point PCR
Agarose gel results are obtained from the end point of the reaction. Endpoint detection is very time consuming. Results may not be obtained for days. Results are based on size discrimination, which may not be very precise. As seen later in the section, the end point is variable from sample to sample. While gels may not be able to resolve these variabilities in yield, real-time PCR is sensitive enough to detect these changes. Agarose Gel resolution is very poor, about 10 fold. Real-Time PCR can detect as little as a two-fold change. Some of the problems with End-Point Detection: Poor Precision, low sensitivity, short dynamic range < 2 logs, low resolution, non - automated, size-based discrimination only, results are not expressed as numbers, ethidium bromide for staining is not very quantitative and requirement for post PCR processing.
Table 16: AOAC -approved rapid microbial test kits
| Test Kit Name | Manufacturer | Analytes |
|---|---|---|
Reveal BIND Salmonella Rapid Assay Kit BAX for Screening Salmonella EiaFoss Salmonella Listeria DLP Assay VIDAS Listeria Assay BAX for Screening E.coli O157:H7 Detex System MC-18 E. coli O157: H7 EiaFoss Listeria ELISA Kit BAX for Screening/Listeria monocytogenes | Neogen Corporation GENE-TRAK Systems Qualicon bioMerieux Qualicon Molecular Circuitry Inc. Foss Electric A/S Qualicon Perkin-Elmer GeneTrak systems | Salmonella spp. Salmonella spp. Salmonella spp. Salmonella spp. Salmonella spp. Listeria monocytogenes. Listeria monocytogenes. E.coli O157:H7 E.coli O157 including H7 Listeria monocytogenes. Listeria monocytogenes. Salmonella E.coli, Salmonella |
 | |||
|---|---|---|---|
| 1 DNA/ RNA Extraction | 2 | 3 | 4 |
| Fig. 7: Conventional PCR- Based testing formats | |||
Real-Time PCR Applications
Real-Time PCR can be applied to traditional PCR applications as well as new applications that would have been less effective with traditional PCR. With the ability to collect data in the exponential growth phase, the power of PCR has been expanded into applications such as: viral quantitation, quantitation of gene expression, array verification, drug therapy efficacy, DNA Damage measurement, quality control and assay validation, pathogen detection and genotyping. The most popular real-time PCR based system used in food authentication is the Qualicons BAX® detection system, which is a fast and accurate test for screening food and environmental samples for pathogens e.g, E. coli O157:H7, Listeria monocytogenes, Enterobacter sakazakii, Salmonella, Campylobacter coli etc (Fig. 8).
![]() Fig. 8: Qualicons BAX system
Fig. 8: Qualicons BAX system
Advantages of using Real-Time PCR
- a) Traditional PCR is measured at End-Point (plateau), while Real-Time PCR collects data in the exponential growth phase
- b) An increase in reporter fluorescent signal is directly proportional to the number of amplicons generated
- c) The cleaved probe provides a permanent record amplification of an Amplicon
- d) Increase dynamic range of detection
- e) No-post PCR processing
- f) Detection is capable down to a 2-fold change
Conclusions
A variety of DNA-based methods are available for use in food authentication which varies in their complexity and cost. Both these factors influence the uptake of such tests by food control laboratories. With increasing regulation of food products, in response to consumer concern, food industry must have strong network of efficient quality assurance programme to monitor the quality and safety of foods before reaching the consumers. This can be possible with the application of recent development in DNA based methods in quality assurance programmes for detecting and identifying microbial pathogens. The sooner the food industry adopts and implements these biotechnological methods, the better for it to make its presence felt both in national and international market.
Suggested Readings
- MR Adams and MO Moss. 2000. Food Microbiology. New Age International (P) Ltd, Publshers.
- James M Jay. 2005. Modern Food Microbiology. IVth Edition. CBS publishers and Distributors, New Delhi.
- C Frazier & DC Westhoff. 2006. Food Microbiology. IVth edition. Tata McGraw Hill Publishing Co. Ltd, New Delhi.
- Bibek Ray. 2000. Fundamental Food Microbiology. CRC Press, New York.
- H. Michael Wehr, Joseph F. Frank.2004. APHA Standard Methods for the Examination of Dairy
- Products. 17th Edition. American Public Health Association.
- F. P. Downes, Keith Ito. 2001. Compendium of Methods for the Microbiological
- Examination of Foods. IVth Edition. American Public Health Association.












